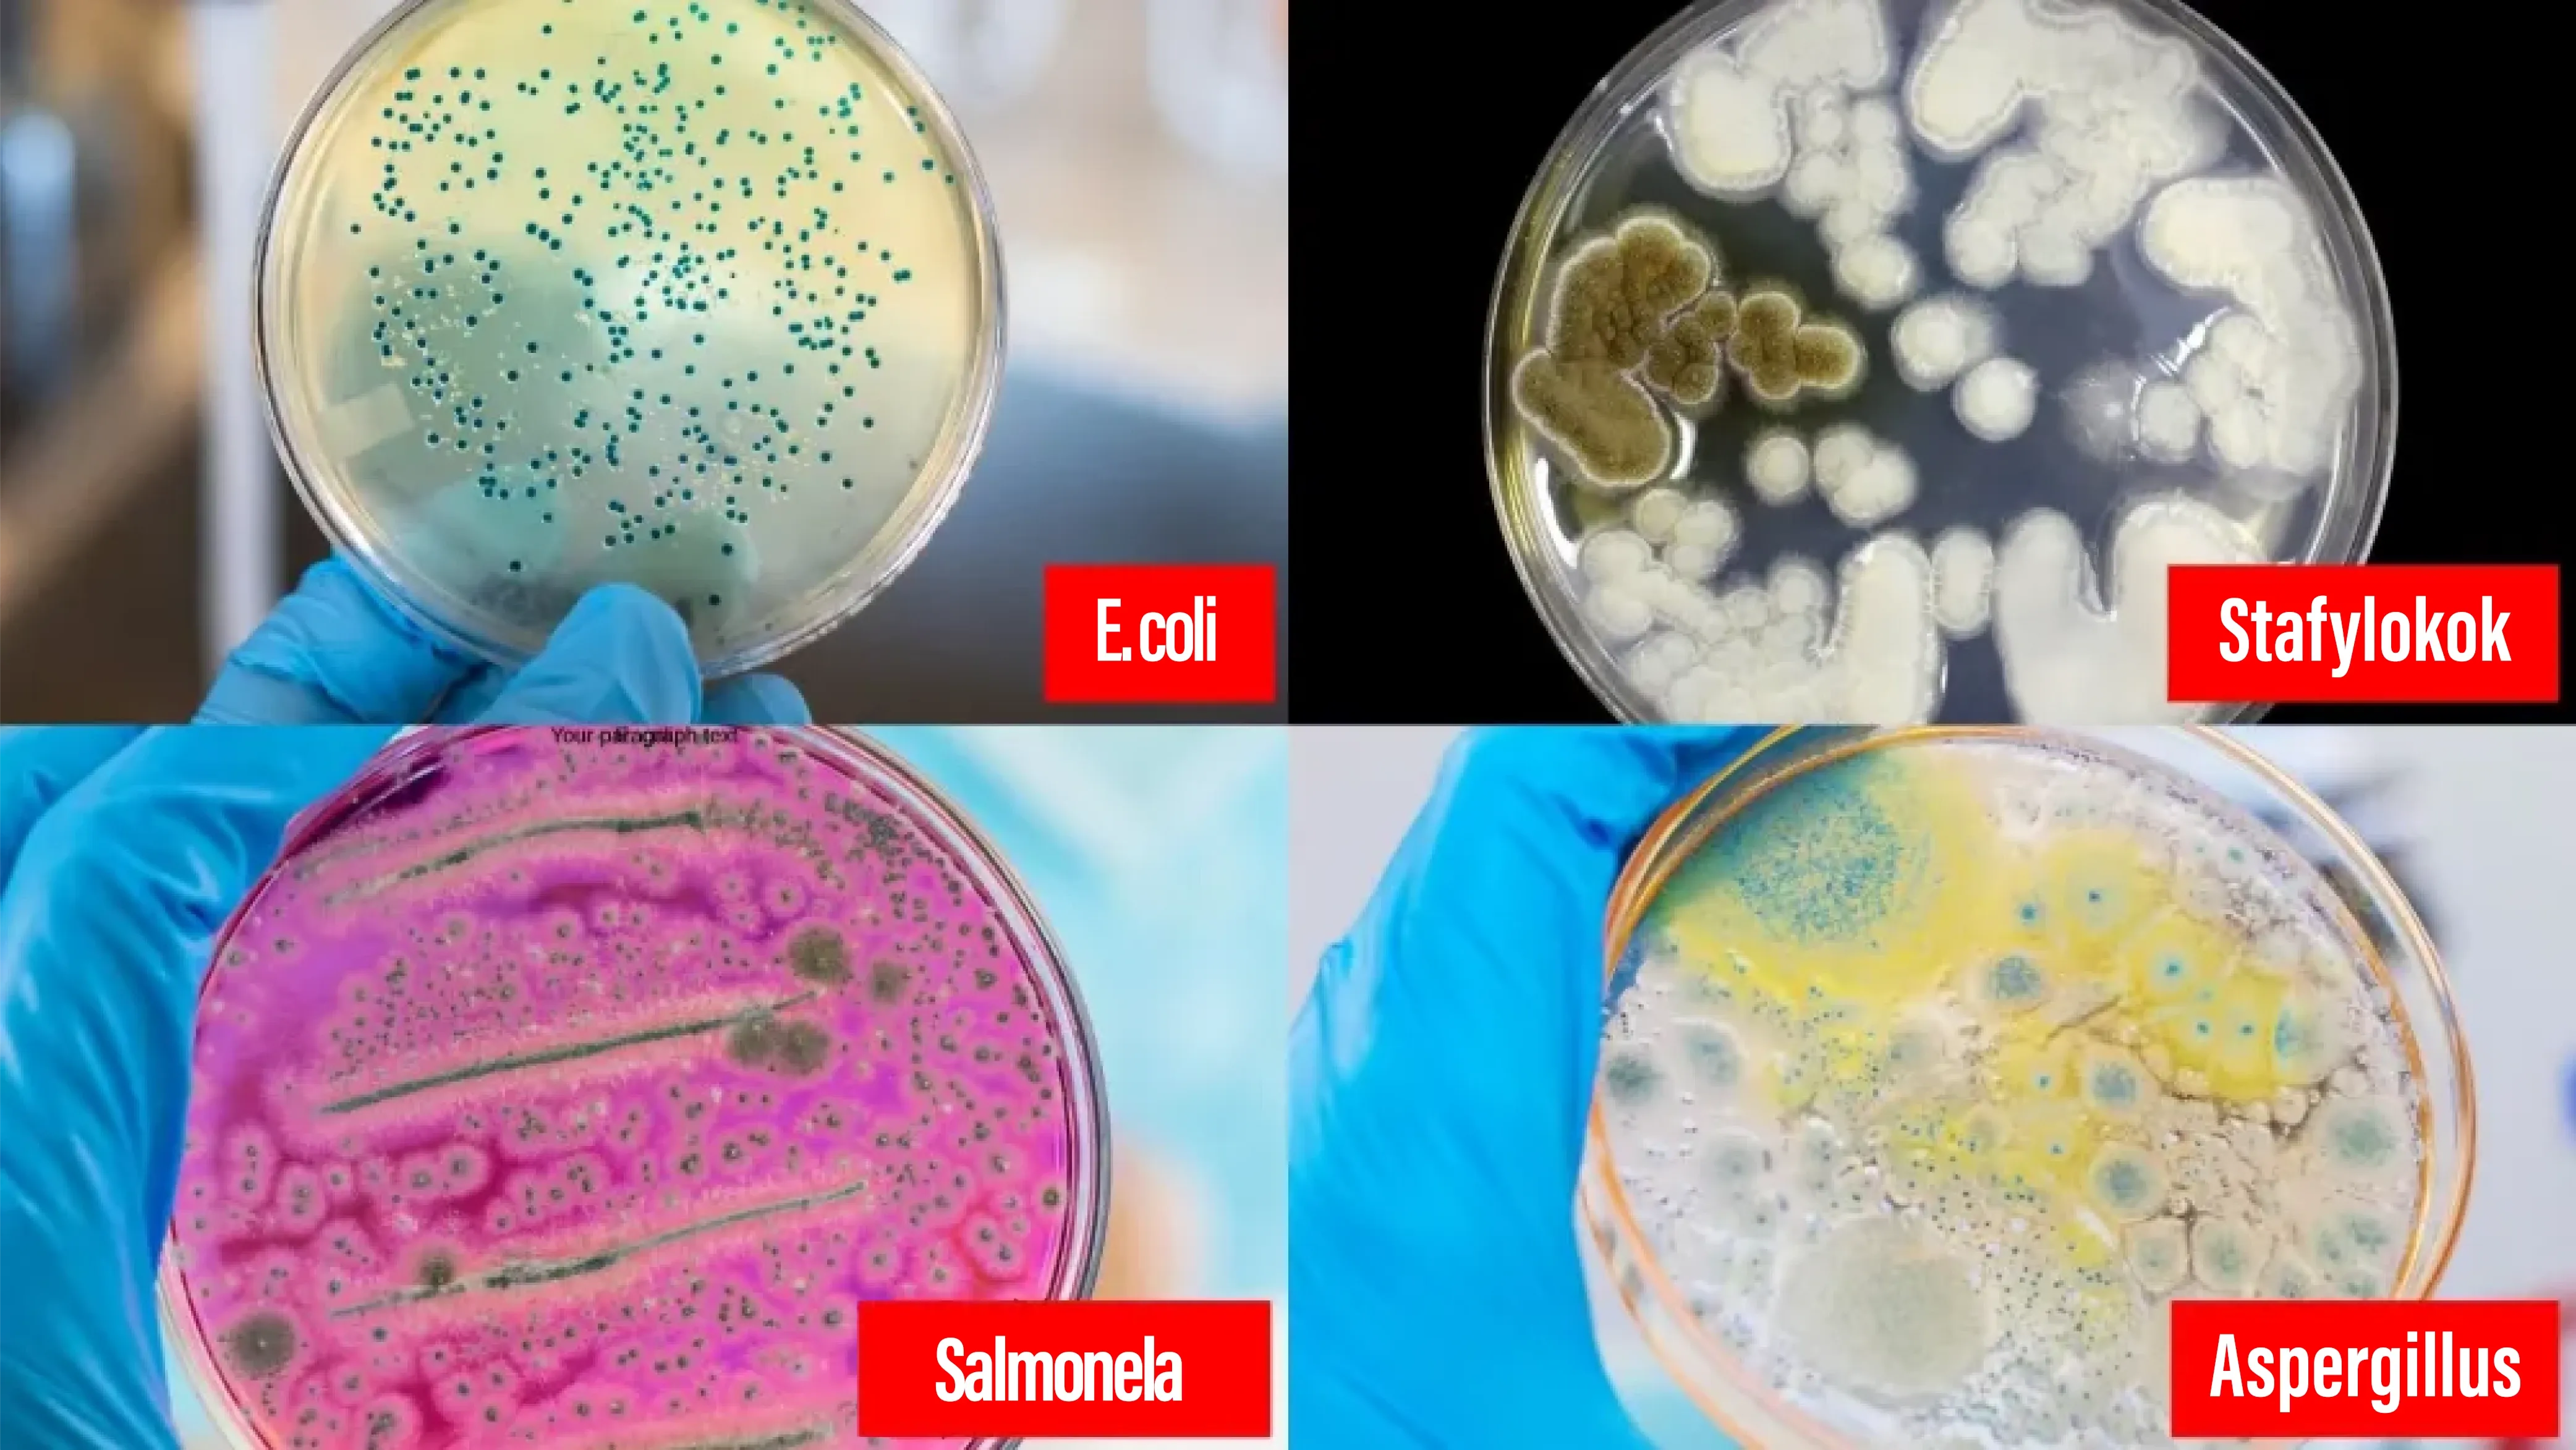

Médicos Renomados Revelam: uma Nova Epidemia Bacteriana em Nossas Casas e os 3 Maiores Erros de Limpeza que Você Está Cometendo Agora e que Estão Piorando a Situação.
AVISO IMPORTANTE: Apenas um número limitado de unidades do Synoshi PRO está disponível com 70% de desconto — o estoque deve se esgotar em 48 horas. Aprovado para uso médico: Elimina 99,7% das bactérias perigosas em minutos.

Andrew Walker 
Se você notou que sua família está adoecendo com mais frequência, se incomoda com odores persistentes ou se tem alergias inexplicáveis que estão piorando em casa, o que você está prestes a aprender pode salvar a saúde da sua família.
No mês passado, tive acesso exclusivo a um simpósio fechado na Universidade de Medicina, onde os principais especialistas em doenças infecciosas se reuniram para discutir uma descoberta perturbadora que chamam de "a crise de saúde oculta em nossos lares".
Eis o que ninguém te conta:
O que os médicos revelaram me deixou sem palavras e realmente me assustou, e comecei a me preocupar com a saúde da minha própria família.
O Dr. Carlos Chagas, um dos maiores especialistas em limpeza ambiental e bactérias, apresentou dados que deixaram até mesmo médicos experientes sem fôlego:
"Em nossas casas, encontramos depósitos de bactérias 300% mais resistentes do que os que tínhamos aqui há cinco anos. E sabe qual é a pior parte? Que o método de limpeza clássico ao qual estamos acostumados a vida toda ainda está ajudando-as."
Um silêncio profundo se fez no salão.
Então ele disse algo que surpreendeu a todos:
"Provavelmente existem entre sete e dez mil tipos diferentes de bactérias escondidas em suas casas neste exato momento. A maioria delas é invisível. Muitas são perigosas. E quase todas prosperam por causa de três erros fundamentais que quase todo eslovaco comete ao limpar."

3 erros comuns de limpeza que transformam sua casa em um ambiente propício para a proliferação de bactérias
Erro 1: Usar as mesmas ferramentas em todos os lugares

"É basicamente a transferência de bactérias de um lugar para outro em sua pior forma", explicou o Dr. Chagas, mostrando imagens ao microscópio que deixaram vários participantes visivelmente nauseados.
Se você usa a mesma esponja, pano ou escova para limpar várias superfícies, na verdade não está limpando — está espalhando os germes por toda a casa.
As imagens mostraram como bactérias de uma escova de vaso sanitário usada apenas uma vez se espalharam para:
Cozinha (onde você prepara a comida)
Maçanetas (você as toca mais de 50 vezes por dia)
Interruptores de luz (nunca limpos adequadamente)
Brinquedos infantis (que as crianças colocam na boca).
Erro 2: Acreditar que “quando parece limpo”, é porque realmente está limpo.

A Dra. Rebeka Turková, médica-chefe do departamento de imunologia pediátrica, revelou as descobertas mais preocupantes:
"Testamos 100 casas que pareciam ter saído direto da caixa. Nenhuma delas atendeu aos nossos padrões de segurança bacteriológica. O que parece limpo muitas vezes é apenas um grande conjunto habitacional repleto de bactérias perigosas."
Ela mostrou fotos de "antes" e "depois" tiradas com um dispositivo especial. Lugares que pareciam completamente limpos se iluminaram como árvores de Natal sob o dispositivo, revelando colônias inteiras:
E. coli (causa problemas digestivos graves)
Estafilococos (causam infecções de pele)
Salmonella (causa de intoxicação alimentar)
Aspergillus (causa problemas respiratórios)
Erro 3: Esfregar com força e velocidade insuficientes
“Eis o que ninguém entende”, disse o Dr. Chagas, apontando para uma escova de dentes comum. “Você provavelmente consegue fazer de 20 a 30 movimentos por minuto com uma escova manual. “Os biofilmes — aqueles escudos protetores que os microrganismos produzem — precisam de pelo menos 195 movimentos por minuto para serem completamente removidos.”
Até 80% da "sujeira" em sua casa é completamente invisível a olho nu.
Urina derramada ao redor dos vasos sanitários. Manchas de sangue nas superfícies. Depósitos de calcário que parecem limpos, mas contêm bactérias.
Você limpou o que podia ver... enquanto os verdadeiros problemas permanecem ocultos.
Não admira que sua casa nunca pareça realmente limpa.
Não admira que você esteja exausto depois de horas esfregando.
Não é de admirar que os convidados às vezes façam aquela cara estranha quando usam seu banheiro.

Uma descoberta da nossa região que revolucionou a limpeza tradicional.
Há seis meses, pesquisadores do Clean Living Laboratory fizeram uma descoberta inovadora que está mudando completamente a forma como os médicos veem a higiene em nossas casas.
Descobriram que a combinação de três elementos específicos pode eliminar até 99,7% das bactérias em casa:
“Pela primeira vez, você realmente vê o que está combatendo”, observou o Dr. Chagas. “É como dar óculos de visão noturna para alguém no escuro.”
A solução japonesa que salva nossas famílias
Durante o segundo dia do simpósio, fomos apresentados a Kenji Nakamura, um dos principais especialistas japoneses em tecnologias de higiene, que veio especialmente para esta apresentação.
“No Japão, eliminamos esses problemas há décadas”, disse ele com naturalidade. “A solução não é trabalhar mais, mas sim trabalhar com sabedoria.”
Em seguida, ele apresentou o Synoshi PRO – um dispositivo que parecia mais um equipamento hospitalar do que um eletrodoméstico comum.

Poucas semanas após o lançamento do Synoshi PRO no mercado, ele se tornou assunto em todos os jornais e na televisão. Notícias nos canais Rede Globo, SBT e Record TV mostraram apresentadores surpresos e impressionados com a descoberta de sujeira invisível sob luz ultravioleta. Nas redes sociais e em vídeos na internet, o Synoshi PRO se tornou um sucesso instantâneo, sendo visto por milhares de pessoas, e especialistas em limpeza o consideraram uma "invenção revolucionária".
"Este é o resultado de 15 anos de pesquisa japonesa sobre a melhor maneira de limpar, e agora foi aprimorado por descobertas médicas americanas inovadoras", explicou o Sr. Nakamura.
Synoshi PRO : Proteja sua família da invasão bacteriana.
Synoshi PRO não é apenas mais um utensílio de limpeza – é um sistema completo de eliminação de germes que corrige todos os erros que as famílias cometem na hora da limpeza:
Tecnologia revolucionária de motor de três velocidades
Baixa velocidade (195 rpm): Limpa com segurança superfícies delicadas sem danificá-las.
Alta velocidade (235 rpm): Destrói biofilme resistente e bactérias depositadas.
Esfregão elétrico rotativo Synoshi Pro é um dispositivo elétrico portátil sem fios que executa a maior parte da sua limpeza. Os aparelhos de limpeza elétricos como este estão na moda no Japão e quase todas as famílias possuem um.
O Synoshi Pro permite-lhe respeitar facilmente as diretivas culturais e religiosas japonesas de limpeza. Só tem de aplicar uma fração do esforço para ter a sua casa limpa.
Basta segurar no dispositivo e direcioná-lo para qualquer superfície para efetuar toda a limpeza.
É uma das tecnologias de limpeza mais recentes e eficazes que conhecemos. O dispositivo foi criado para combinar o amor do Japão pela limpeza e pela tecnologia moderna num produto acessível a todos. As pessoas estão a delirar com este produto na Internet desde o seu lançamento.

O dispositivo possui um design inovador em forma de L. A cabeça da escova é fixada na extremidade pontiaguda. É possível utilizar as sete cabeças de escova incluídas na caixa para limpar um vasto leque de superfícies, garantindo praticidade e eficiência em qualquer tipo de limpeza.
Onde quer que haja sujidade (espaços apertados, cantos ou superfícies lisas), o Synoshi Pro consegue chegar até ela.
Quando limpa com o Synoshi Pro, não precisa de passar horas a esfregar, passar a esfregona e a limpar. Reduz o tempo de limpeza para mais de metade e elimina a maior parte do stress associado à limpeza.

O que torna este dispositivo tão impressionante?
Detecção UV Revolucionária: O Synoshi revela sujeira e manchas escondidas que você não consegue ver a olho nu. Respingos de urina, sangue, calcário… tudo aquilo que deixa sua casa com sensação de suja mesmo quando parece limpa.
Sistema de Ângulo Inteligente: Ajusta nos ângulos de 0°, 36° e 72°. Limpe o teto sem precisar de escada, o chão sem ficar se curvando e alcance atrás do vaso sanitário sem precisar se contorcer.
Bateria Estendida de até 6 Horas: A bateria de 2000 mAh funciona por até 6 horas seguidas. Dá pra limpar a casa inteira com uma única carga, sem parar no meio do serviço.
Leve e Sem Fio: Chega de arrastar equipamentos pesados ou ficar se enrolando em fios enquanto tenta limpar aquela sujeira escondida nos cantinhos do banheiro. Com apenas 414g, o Synoshi Pro é leve e fácil de manusear, alcançando todos os lugares onde as bactérias se escondem, sem cansar seus braços nem gerar frustração.
Sistema Modular de Acessórios : São 7 cabeças de limpeza diferentes pra cada tipo de superfície. Do vidro mais delicado até os rejuntes mais difíceis. Um único aparelho, várias possibilidades.

Os métodos tradicionais de limpeza são cansativos, demorados e exigem um esforço físico enorme — especialmente quando você precisa esfregar pisos, rejuntes ou o banheiro por longos minutos. Diferente disso, o Synoshi PRO pode ir a qualquer lugar da casa com facilidade, ajudando você a remover sujeiras difíceis sem precisar se ajoelhar, forçar as costas ou gastar horas limpando.
Uma coisa é certa: depois de experimentar o Synoshi PRO, você dificilmente vai querer voltar para as escovas e esfregões tradicionais!
99% dos usuários recomendam Synoshi PRO para seus amigos e familiares.

Antonio Silva
 Casa limpa esposa feliz.
Casa limpa esposa feliz.
Compra verificada
"Comprei o Synoshi no mês passado e ele realmente faz jus à fama. É muito fácil de usar e a duração da bateria é impressionante. Minha esposa está muito feliz com a limpeza da cozinha... e tem sido uma bênção para as minhas dores nas articulações.."


Karina Helena
 minha filha salvou a minha vida com o Synoshi PRO.
minha filha salvou a minha vida com o Synoshi PRO.
Compra verificada
"Achei que minha história como faxineira estava acabando. As dores nas costas e nos joelhos não me deixavam mais agachar nem terminar os serviços, e eu tinha medo de perder meu trabalho. Minha filha apareceu com o Synoshi PRO e disse pra eu tentar antes de desistir. Hoje eu limpo sem sofrer, consigo trabalhar e ainda voltar pra casa com energia. Filha, você não me deu só um aparelho… você me devolveu a dignidade. Obrigada ❤️"


Estevão Moraes
 Antes era metade do meu sabado para dar uma geral na casa, mas eu não tinha o Synoshi PRO!
Antes era metade do meu sabado para dar uma geral na casa, mas eu não tinha o Synoshi PRO!
Compra verificada
"Limpar não é exatamente a minha ideia de diversão, mas a gente tem que fazer o que tem que fazer, então resolvi testar esse aparelho. Sem grandes expectativas, só esperando uma ajudinha. E, para minha surpresa, não é tão ruim assim. Sem fios para atrapalhar, limpa bem lá no fundo e até a sujeira mais difícil.

Algumas perguntas que recebemos:
P: O Synoshi PRO precisa de instalação?
"Não, é só tirar da caixa e começar a usar, é muito simples. Em poucos segundos você já consegue começar a limpeza em qualquer lugar da casa."
P: Posso usar o Synoshi PRO sem fazer esforço ou por muito tempo?
"Com certeza. Ele é leve, sem fio e feito justamente pra não cansar os braços nem forçar as costas ou os joelhos. Dá pra limpar com conforto, até nas áreas mais difíceis.”
Os custos ocultos da contaminação bacteriana
Pense em quanto essas bactérias domésticas estão realmente custando à sua família:
Consultas médicas por doenças "misteriosas": 200 a 500 reais
Medicamentos para alergia: 50 a 200 reais
Limpeza profissional profunda: 300 a 600 reais
Subsídio de doença: 250 a 500 reais
Atendimento de emergência devido a infecção grave: 1.500 a 3.000 reais
Custo potencial total: R$ 5.000 a R$ 10.000 por ano.
Investir no Synoshi PRO? Menos de uma consulta médica.
Por que os médicos recomendam o Synoshi PRO?
A Dra. Turková encerrou o simpósio com a seguinte declaração:
"Se cada lar eslovaco tivesse um dispositivo Synoshi PRO, veríamos uma redução de até 60% no número de infecções domésticas. Isso representa um milhão de doenças prevenidas anualmente. Não se trata mais apenas de manter a casa limpa — trata-se da saúde de todos nós."
Nossos especialistas em higiene e limpeza agora nos aconselham a usar máquinas de limpeza modernas em casa se quisermos ter um lar verdadeiramente saudável e seguro.

Quanto custa o Synoshi PRO?
Considerando as tecnologias e funcionalidades do Synoshi PRO não seria nenhuma surpresa ver um preço de até R$1400. O que ainda seria baixo em comparação a maioria dos equipamentos profissionais de limpeza tradicionais (eles geralmente custam mais de R$4000).
O preço normal de varejo é R$990, muito menor que esperávamos.
Mas, sabe o que é melhor do que pagar um preço baixo? Um desconto de 70% para que você possa comprar por apenas R$297 com frete grátis para todo o Brasil! (Promoção válida até )
Não tenho mais nada a dizer. Você quer finalmente ter uma casa realmente limpa, sem esforço e sem passar horas esfregando? Clique aqui. Agora. Antes que a promoção termine.
Esse é um pequeno investimento por um equipamento moderno, potente e eficiente, capaz de transformar completamente a forma como você limpa sua casa todos os dias.
Como pode ser tão acessível?
As grandes marcas de equipamentos de limpeza profissional gastam bilhões anualmente em publicidade, marketing e lojas físicas. E, pensando bem, nós, os consumidores, somos quem realmente paga por isso.
A Synoshi não gasta nada com isso. Eles vendem apenas online, não anunciam na TV e não pagam comissões.
Eles realmente deixam que seus dispositivos e avaliações positivas façam as vendas por eles.
Clique aqui para verificar se a promoção do Synoshi PRO ainda está disponível.
Conclusão: Você deveria comprar?
Com certeza, 100% SIM!!
O esfregão elétrico Synoshi PRO já valia a pena mesmo antes do desconto, e com o frete grátis como bônus, não há literalmente mais nada a ser discutido.
Você quer uma casa realmente limpa SEM passar horas esfregando ou acabar com dor nas costas depois? Então chegou a hora de tomar uma decisão que mudará sua vida!
Você logo entenderá por que milhares de pessoas em todo o país estão encomendando!
Chegou a hora de finalmente limpar sua casa sem esforço, sem estresse e sem perder o fim de semana inteiro esfregando banheiro e cozinha.
Se você quer limpar sem dor nas costas, acabar com a sujeira pesada sem esforço e deixar sua casa realmente higienizada, até aquelas bactérias invisíveis que ficam escondidas no banheiro e na cozinha, este aparelho faz tudo isso e muito mais.
Possui os recursos mais avançados de 2026, mas custa muito menos. Se ainda estiver à venda por menos de R$ 300,00, não hesite e compre um antes que acabe o estoque.
Resumindo: Nós ADORAMOS! Você não encontrará uma ferramenta de limpeza tão eficiente por um preço tão baixo.
Prós:
Muito fácil de usar.
Ultraleve e portátil.
Elimina resíduos invisíveis como gordura, mofo e bactérias escondidas nas superfícies.
Silencioso e reduz em até 40% o tempo e o gasto com produtos de limpeza.
Contras:
- Disponível apenas no site oficial.
Como adquirir um Synoshi PRO?
Agora que você já conhece esse novo produto incrível, e caso ainda esteja disponível, veja como conseguir um:
Recomendamos encomendar um Synoshi PRO original no site oficial do fornecedor clicando aqui.
Desfrute de uma casa limpa sem dor e sem estresse.
Clique aqui para verificar se a promoção do Synoshi PRO ainda está disponível.

PROMOÇÃO ESPECIAL: Por tempo limitado, aproveite 70% de desconto e frete grátis! A empresa está atendendo à alta demanda após a publicação deste artigo. Você ganha 70% de desconto se comprar hoje, somente no site oficial. Aproveite antes que o estoque acabe!
Garanta já o seu pedido com 70% OFF + ENTREGA RÁPIDA para todo Brasil
Clique aqui para garantir seu Synoshi PRO com 70% de desconto e frete grátis.












